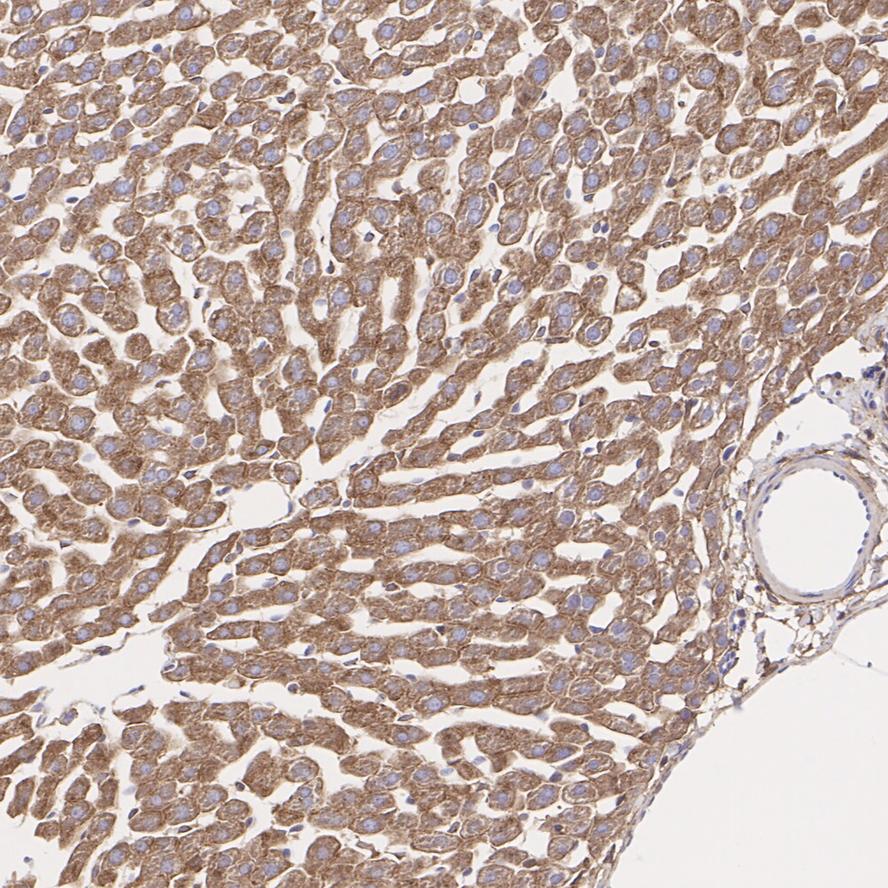

Rmb: 618 1500 特惠 1500
产品规格
Catalog# ET1601-1
LRP1 Recombinant Rabbit Monoclonal Antibody [SA0290]
-
WB
-
IF-Tissue
-
IHC-P
-
IP
-
IHC-Fr
-
Human
-
Mouse
-
Rat
-
unconjugated
Safety datasheet
概述
产品名称
LRP1 Recombinant Rabbit Monoclonal Antibody [SA0290]
抗体类型
Recombinant Rabbit monoclonal Antibody
免疫原
Synthetic peptide within Human LRP1 aa 4,471-4,520 / 4,544.
种属反应性
Human, Mouse, Rat
验证应用
WB, IF-Tissue, IHC-P, IP, IHC-Fr
分子量
Predicted band size: 505 kDa
阳性对照
Mouse liver tissue lysate, Human lung tissue lysate, Rat liver tissue lysate, Rat lung tissue lysate, Mouse lung tissue lysate, Human liver tissue lysate, mouse brain tissue, rat brain tissue, rat liver tissue, human lung tissue, human liver tissue, mouse liver tissue.
偶联
unconjugated
克隆号
SA0290
RRID
产品特性
形态
Liquid
浓度
存放说明
Shipped at 4℃. Store at +4℃ short term (1-2 weeks). Store at -20℃ long term.
存储缓冲液
1*TBS (pH7.4), 0.05% BSA, 40% Glycerol. Preservative: 0.05% Sodium Azide.
亚型
IgG
纯化方式
Protein A affinity purified.
应用稀释度
-
WB
-
1:1,000-1:5,000
-
IF-Tissue
-
1:50
-
IHC-P
-
1:200-1:2,000
-
IP
-
1-2μg/sample
-
IHC-Fr
-
1:100
靶点
功能
LRP1 is a member of the LDLR family and ubiquitously expressed in multiple tissues, though it is most abundant in vascular smooth muscle cells (SMCs), hepatocytes, and neurons. LRP1 plays a key role in intracellular signaling and endocytosis, which thus implicate it in many cellular and biological processes, including lipid and lipoprotein metabolism, protease degradation, platelet derived growth factor receptor regulation, integrin maturation and recycling, regulation of vascular tone, regulation of blood brain barrier permeability, cell growth, cell migration, inflammation, and apoptosis, as well as diseases such as neurodegenerative diseases, atherosclerosis, and cancer. The LRP1 gene encodes a 600 kDa precursor protein that is processed by furin in the trans-Golgi complex, resulting in a 515 kDa alpha-chain and an 85 kDa beta-chain associated noncovalently.
背景文献
1. Fernandez-Castaneda, A. et al. 2013. Identification of the low density lipoprotein (LDL) receptor-related protein-1 interactome in central nervous system myelin suggests a role in the clearance of necrotic cell debris. J. Biol. Chem. 288: 4538-4548.
2. Yahiro, K. et al. 2012. Low-density lipoprotein receptor-related protein-1 (LRP1) mediates autophagy and apoptosis caused by Helicobacter pylori VacA. J. Biol. Chem. 287: 31104-31115.
序列相似性
Belongs to the LDLR family.
组织特异性
Most abundant in liver, brain and lung.
翻译后修饰
Cleaved into a 85 kDa membrane-spanning subunit (LRP-85) and a 515 kDa large extracellular domain (LRP-515) that remains non-covalently associated. Gamma-secretase-dependent cleavage of LRP-85 releases the intracellular domain from the membrane.; The N-terminus is blocked.; Phosphorylated on serine and threonine residues.; Phosphorylated on tyrosine residues upon stimulation with PDGF. Tyrosine phosphorylation promotes interaction with SHC1.
亚细胞定位
Cytoplasm, Nucleus, Membrane.
别名
A2MR antibody
Alpha 2 macroglobulin receptor antibody
alpha 2MR antibody
Alpha-2-macroglobulin receptor antibody
APOER antibody
Apolipoprotein E receptor antibody
APR antibody
CD 91 antibody
CD91 antibody
CD91 antigen antibody
展开A2MR antibody
Alpha 2 macroglobulin receptor antibody
alpha 2MR antibody
Alpha-2-macroglobulin receptor antibody
APOER antibody
Apolipoprotein E receptor antibody
APR antibody
CD 91 antibody
CD91 antibody
CD91 antigen antibody
IGFBP3R antibody
LDL receptor related protein 1 antibody
Low density lipoprotein receptor related protein 1 antibody
Low density lipoprotein related protein 1 antibody
Low-density lipoprotein receptor-related protein 1 intracellular domain antibody
LRP 1 antibody
LRP 515 antibody
LRP 85 antibody
LRP antibody
LRP ICD antibody
LRP-1 antibody
LRP-515 antibody
LRP-85 antibody
Lrp1 antibody
LRP1 protein antibody
LRP1_HUMAN antibody
LRP1A antibody
LRP515 antibody
LRP85 antibody
LRPICD antibody
MGC88725 antibody
Prolow density lipoprotein receptor related protein 1 antibody
TbetaR V/LRP 1/IGFBP 3 receptor antibody
TbetaRV/LRP1/IGFBP3 receptor antibody
TGFBR 5 antibody
TGFBR5 antibody
Type V tgf beta receptor antibody
Low-density lipoprotein receptor-related protein 1 85 kDa subunit
折叠图片
-

☑ Knockdown (KD)
All lanes: Western blot analysis of LRP1 with anti-LRP1 antibody (ET1601-1) at 1:1,000 dilution.
Lane 1: Wild-type Hela whole cell lysate (10 µg).
Lane 2/3: LRP1 knockdown Hela whole cell lysate (10 µg).
ET1601-1 was shown to specifically react with LRP1 in wild-type Hela cells. Weakened bands were observed when LRP1 knockdown samples were tested. Wild-type and LRP1 knockdown samples were subjected to SDS-PAGE. Proteins were transferred to a PVDF membrane and blocked with 5% NFDM in TBST for 1 hour at room temperature. The primary antibody (ET1601-1, 1/1,000) was used in 5% BSA at room temperature for 2 hours. Goat Anti-Rabbit IgG-HRP Secondary Antibody (HA1001) at 1:300,000 dilution was used for 1 hour at room temperature. -

Immunohistochemical analysis of paraffin-embedded mouse brain tissue with Rabbit anti-LRP1 antibody (ET1601-1) at 1/2,000 dilution.
The section was pre-treated using heat mediated antigen retrieval with sodium citrate buffer (pH 6.0) (high pressure) for 2 minutes. The tissues were blocked in 1% BSA for 20 minutes at room temperature, washed with ddH2O and PBS, and then probed with the primary antibody (ET1601-1) at 1/2,000 dilution for 1 hour at room temperature. The detection was performed using an HRP conjugated compact polymer system. DAB was used as the chromogen. Tissues were counterstained with hematoxylin and mounted with DPX. -

Immunohistochemical analysis of paraffin-embedded rat brain tissue with Rabbit anti-LRP1 antibody (ET1601-1) at 1/2,000 dilution.
The section was pre-treated using heat mediated antigen retrieval with sodium citrate buffer (pH 6.0) (high pressure) for 2 minutes. The tissues were blocked in 1% BSA for 20 minutes at room temperature, washed with ddH2O and PBS, and then probed with the primary antibody (ET1601-1) at 1/2,000 dilution for 1 hour at room temperature. The detection was performed using an HRP conjugated compact polymer system. DAB was used as the chromogen. Tissues were counterstained with hematoxylin and mounted with DPX. -

Immunohistochemical analysis of paraffin-embedded rat liver tissue with Rabbit anti-LRP1 antibody (ET1601-1) at 1/5,000 dilution.
The section was pre-treated using heat mediated antigen retrieval with sodium citrate buffer (pH 6.0) (high pressure) for 2 minutes. The tissues were blocked in 1% BSA for 20 minutes at room temperature, washed with ddH2O and PBS, and then probed with the primary antibody (ET1601-1) at 1/5,000 dilution for 1 hour at room temperature. The detection was performed using an HRP conjugated compact polymer system. DAB was used as the chromogen. Tissues were counterstained with hematoxylin and mounted with DPX. -

Immunohistochemical analysis of paraffin-embedded human lung tissue with Rabbit anti-LRP1 antibody (ET1601-1) at 1/200 dilution.
The section was pre-treated using heat mediated antigen retrieval with sodium citrate buffer (pH 6.0) (high pressure) for 2 minutes. The tissues were blocked in 1% BSA for 20 minutes at room temperature, washed with ddH2O and PBS, and then probed with the primary antibody (ET1601-1) at 1/200 dilution for 1 hour at room temperature. The detection was performed using an HRP conjugated compact polymer system. DAB was used as the chromogen. Tissues were counterstained with hematoxylin and mounted with DPX. -
Immunohistochemical analysis of paraffin-embedded human liver tissue with Rabbit anti-LRP1 antibody (ET1601-1) at 1/2,000 dilution.
The section was pre-treated using heat mediated antigen retrieval with sodium citrate buffer (pH 6.0) (high pressure) for 2 minutes. The tissues were blocked in 1% BSA for 20 minutes at room temperature, washed with ddH2O and PBS, and then probed with the primary antibody (ET1601-1) at 1/2,000 dilution for 1 hour at room temperature. The detection was performed using an HRP conjugated compact polymer system. DAB was used as the chromogen. Tissues were counterstained with hematoxylin and mounted with DPX. -

Immunohistochemical analysis of paraffin-embedded mouse liver tissue with Rabbit anti-LRP1 antibody (ET1601-1) at 1/200 dilution.
The section was pre-treated using heat mediated antigen retrieval with sodium citrate buffer (pH 6.0) (high pressure) for 2 minutes. The tissues were blocked in 1% BSA for 20 minutes at room temperature, washed with ddH2O and PBS, and then probed with the primary antibody (ET1601-1) at 1/200 dilution for 1 hour at room temperature. The detection was performed using an HRP conjugated compact polymer system. DAB was used as the chromogen. Tissues were counterstained with hematoxylin and mounted with DPX. -

Immunofluorescence analysis of frozen mouse hippocampus tissue labeling LRP1 with Rabbit anti-LRP1 antibody (ET1601-1).
The tissues were blocked in 3% BSA for 30 minutes at room temperature, washed with PBS, and then probed with the primary antibody (ET1601-1, green) at 1/100 dilution overnight at 4℃, washed with PBS. Goat Anti-Rabbit IgG H&L (Alexa Fluor® 488) was used as the secondary antibody at 1/200 dilution. Nuclei were counterstained with DAPI (blue). Image acquisition was performed with KFBIO KF-FL-400 Scanner. -

Immunofluorescence analysis of frozen mouse cerebral cortex tissue labeling LRP1 with Rabbit anti-LRP1 antibody (ET1601-1).
The tissues were blocked in 3% BSA for 30 minutes at room temperature, washed with PBS, and then probed with the primary antibody (ET1601-1, green) at 1/100 dilution overnight at 4℃, washed with PBS. Goat Anti-Rabbit IgG H&L (Alexa Fluor® 488) was used as the secondary antibody at 1/200 dilution. Nuclei were counterstained with DAPI (blue). Image acquisition was performed with KFBIO KF-FL-400 Scanner. -

LRP1 was immunoprecipitated from 0.2 mg HeLa cell lysate with ET1601-1 at 2 µg/10 µl beads. Western blot was performed from the immunoprecipitate using ET1601-1 at 1/1,000 dilution. Anti-Rabbit IgG for IP Nano-secondary antibody (NBI01H) at 1/5,000 dilution was used for 1 hour at room temperature.
Lane 1: HeLa cell lysate (input)
Lane 2: ET1601-1 IP in HeLa cell lysate
Lane 3: Rabbit IgG instead of ET1601-1 in HeLa cell lysate
Blocking/Dilution buffer: 5% NFDM/TBST
Exposure time: 3 minutes; ECL: K1801 -

Western blot analysis of LRP1 on different lysates with Rabbit anti-LRP1 antibody (ET1601-1) at 1/5,000 dilution.
Lane 1: Mouse liver tissue lysate
Lane 2: Rat liver tissue lysate
Lysates/proteins at 40 µg/Lane.
Exposure time: 5 seconds; ECL: K1801
Blocking: 5% NFDM/TBST, 1 hour at room temperature
Primary antibody: ET1601-1, 1/5,000 in primary antibody dilution buffer (K1803), overnight at 4 ℃
Secondary antibody: Goat anti-Rabbit IgG-HRP (HA1001), 1/5,000 in 5% NFDM/TBST, 1 hour at room temperature
Predicted band size: 504.6 kDa
Observed band size: 80 kDa
请注意: All products are "FOR RESEARCH USE ONLY AND ARE NOT INTENDED FOR DIAGNOSTIC OR THERAPEUTIC USE"
引文
-
Schisandra chinensis lignans exerts endocannabinoids-like antidepressive effect: The phagocytotic relationship of activated CB2R-mediated M2 microglia and “stressed-but-viable” neuron
期刊: Journal Of Ethnopharmacology
DOI:
IF: 4.8
应用: WB
反应种属: Mouse,Rat
发表时间: 2025 Jan
-
Schisandra chinensis lignans exerts endocannabinoids-like antidepressive effect: The phagocytotic relationship of activated CB2R-mediated M2 microglia and “stressed-but-viable” neuron
期刊: JOURNAL OF ETHNOPHARMACOLOGY
DOI: 10.1016/j.jep.2025.119385
IF: 5.4
应用: WB
反应种属: Rat,Mouse
发表时间: 2025 Jan
-
Triple-targeting nanosystems with synergistic effects on iron Trojan horse, fluoroquinolone antibiotics, and photodynamic therapy specifically kill intracellular MRSA
期刊: Theranostics
DOI: 10.7150/thno.109374
IF: 13.3
应用: FC,IF-Cell
反应种属: Mouse
发表时间: 2025 Aug
-
Paraquat exposure triggers amyloid-β and α-synuclein aggregation in the prefrontal cortex of mice: Suppression of microglial phagocytosis via IL-17A
期刊: International Immunopharmacology
DOI: 10.1016/j.intimp.2025.114746
IF: 4.8
应用: WB
反应种属: Mouse
发表时间: 2025 Apr





 浙公网安备 33019202000643号
浙公网安备 33019202000643号